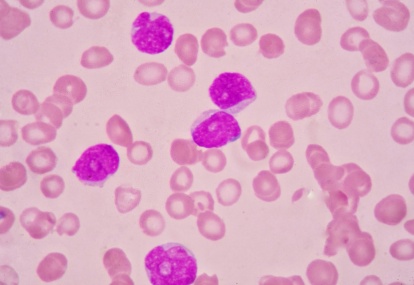

Haematology: Chronic lymphocytic leukaemia
Chronic lymphocytic leukaemia (CLL) is a malignant proliferation of mature B cells, which presents clinically with a circulating peripheral blood lymphocytosis. It is the most common adult leukaemia in the western world and affects males more frequently than females (1.7:1).1
CLL affects 4.5 per 100,000...
Read more